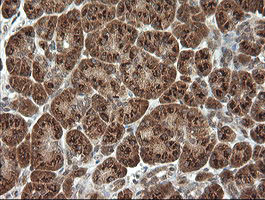
PIK3CG Antibody in Immunohistochemistry (Paraffin) (IHC (P))

Search
OriGene
PIK3CG Monoclonal Antibody (OTI2B1), TrueMAB™
{{$productOrderCtrl.translations['antibody.pdp.commerceCard.promotion.promotions']}}
{{$productOrderCtrl.translations['antibody.pdp.commerceCard.promotion.viewpromo']}}
{{$productOrderCtrl.translations['antibody.pdp.commerceCard.promotion.promocode']}}: {{promo.promoCode}} {{promo.promoTitle}} {{promo.promoDescription}}. {{$productOrderCtrl.translations['antibody.pdp.commerceCard.promotion.learnmore']}}
产品信息
TA505221
种属反应
宿主/亚型
分类
类型
克隆号
抗原
偶联物
形式
浓度
规格
纯化类型
保存液
内含物
保存条件
运输条件
靶标信息
PIK3CG (p110 gamma) is the sole class IB phosphatidylinositol 3-kinase family member, which along with the class IA family members, generates the important second messenger PIP2. However, unlike the class IA enzymes which signal downstream of receptor tyrosine kinases, PIK3CG primarily signals downstream of GPCRs. The gene product is an enzyme that phosphorylates phosphoinositides on the 3-hydroxyl group of the inositol ring. It is an important modulator of extracellular signals, including those elicited by E-cadherin-mediated cell-cell adhesion, which plays an important role in maintenance of the structural and functional integrity of epithelia. In addition to its role in promoting assembly of adherens junctions, the protein is thought to play a pivotal role in the regulation of cytotoxicity in NK cells. The gene is located in a commonly deleted segment of chromosome 7 previously identified in myeloid leukemias.
仅用于科研。不用于诊断过程。未经明确授权不得转售。
篇参考文献 (0)
生物信息学
蛋白别名: 1-phosphatidylinositol 3-kinase; catalytic subunit; p110-gamma; p120-PI3K; phosphatidylinositol 3 kinase gamma, p110 gamma; phosphatidylinositol 3-kinase catalytic 110-kD gamma; Phosphatidylinositol 4,5-bisphosphate 3-kinase 110 kDa catalytic subunit gamma; Phosphatidylinositol 4,5-bisphosphate 3-kinase catalytic subunit gamma isoform; phosphatidylinositol-4,5-bisphosphate 3-kinase 110 kDa catalytic subunit gamma; Phosphoinositide-3-kinase catalytic gamma polypeptide; phosphoinositide-3-kinase gamma catalytic subunit; PI3-kinase subunit gamma; pi3kcg; ptdIns-3-kinase subunit gamma; PtdIns-3-kinase subunit p110-gamma; Serine/threonine protein kinase PIK3CG; unnamed protein product
基因别名: IMD97; p110gamma; p120-PI3K; PI3CG; PI3K; PI3Kgamma; PIK3; PIK3CG
UniProt ID: (Human) P48736
Entrez Gene ID: (Human) 5294